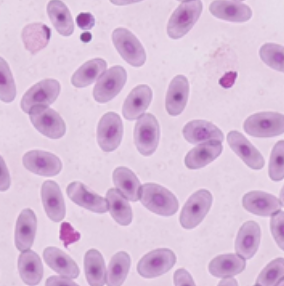
Analyses

Applicables au 1er janvier 2026
Grille Tarifaire 2026
#nospatientssontlesplusbeaux
🩺 Consultations
- Consultation standard 49,00 €
- Urgence (dimanches/fériés) 94,00 €
- Second avis ou référé 94,00 €

🩹 Gestion de la Douleur
- Protocoles multimodaux Inclus
- Monitoring Douleur Inclus
💉 Vaccinations
- Chiens
- Essentiels (CHPPi L2 ou L4) 67,50 €
- Leishmaniose (Letifend) 95,00 €
- Chats
- Chat d’intérieur (RCP) 68,00 €
- Chat d’extérieur (FeLV RCP) 85,00 €
- NAC
- Lapins (Myxo et VHD) 81,50 €
- Furets (Maladie de Carré) 69,50 €
🚫 Avis : Nous disons non à l’antiparasitaire injectable 12 mois (dit aussi « vaccin contre les puces »).

✨ Stérilisations
- Chiens
- Femelle (Ovariectomie) 297,50 – 407,60 €
- Mâle (Castration) 171,30 – 231,30 €
- Chats
- Femelle (Ovariectomie) 157,50 €
- Mâle (Castration) 91,50 €
- NAC
- Femelle (Lapine/Rongeur) 218,60 €
- Mâle (Lapin/Rongeur) 126,60 €

🦷 Soins Dentaires
- Détartrage Chiens 148,90 – 191,60 €
- Détartrage Chats 136,20 €
- Limage dentaire Lapins 114,20 €

📸 Imagerie
- Radio (Thorax/Abdo) 84,30 €
- Radio (Osseux) 79,00 €
- Écho Abdomen 107,00 €
- Échocardiographie 190,60 €
- Endoscopie Sur demande
🔬 Laboratoire
- Analyse sanguine 158,20 €
- Analyse urinaire 51,00 €
- Biochimie NAC dès 30,00 €
Tarifs Laboratoire : Focus sur nos analyses Idexx & Laboklin
Nous utilisons les plateaux techniques de référence mondiale pour garantir la précision diagnostique de nos soins. Voici les examens les plus fréquents disponibles via notre moteur de recherche.
Médecine Chien & Chat (Idexx)
- • Bilan Gériatrique & SDMA : Dépistage précoce des reins.
- • Dosage Progestérone : Suivi de reproduction.
- • Test 4Dx Plus : Maladies vectorielles (Tiques, Dirofilariose 06).
- • Cytologie : Analyse immédiate de masses cutanées.
- • Titrage Rage : Certificats pour l’exportation.
Spécialisation NAC (Laboklin)
- • PCR Tortue : Herpès virus et Mycoplasmes.
- • Bilan Reptile complet : Pogona, Iguane, Varan (Goutte).
- • Sexage génétique : Oiseaux et reptiles par ADN.
- • Profil Lapin : E. cuniculi.
- • Histopathologie : Analyse spécialisée de biopsies.
Note : Ces tarifs sont consultables via notre moteur de recherche ci-dessus en tapant le nom de l’analyse.
Saisissez un mot-clé (ex: T4, Cortisol).
Nos tarifs en partenariat avec LABOKLIN (2025-2026)
Le tarif comprend : la facturation à Laboklin, la préparation de l’échantillon, l’analyse du compte rendu et son suivi client.
Prix hors transport (15,5 euros coursier)
Saisissez un mot-clé pour afficher les tarifs mis à jour.


